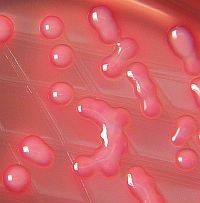
Az egész világot fenyegetik az antibiotikumoknak ellenálló baktériumok

Az egész világot fenyegetik az antibiotikumoknak ellenálló, úgynevezett szuperbaktériumok - olvasható az Egészségügyi Világszervezet (WHO) jelentésében.
A halálos szuperbaktériumok még a legerősebb antibiotikumokra sem reagálnak, elterjedésük pedig már nem jóslat, hanem az egész világon valóság. Bárkit, bármilyen életkorban, bármelyik országban elérhetnek az antibiotikumokra rezisztens baktériumok. A közegészségügyre komoly veszélyt jelentenek, a következmények "pusztítóak lesznek" - közölték a WHO szakemberei.
Az egész világot fenyegetik az antibiotikumoknak ellenálló baktériumok
Forrás: EgészségKalauz
"Az antibiotikumok utáni kor felé tart a világ. A közönséges fertőzések és kisebb sérülések évtizedeken át gyógyíthatók voltak, most pedig újra gyilkolhatnak" - jelentette ki Fukuda Keidzsi, a WHO egészségbiztonsági vezetőjének helyettese.
A WHO 114 ország adatait elemezte első jelentésében az antibiotikum-rezisztenciáról, és szakemberei azt találták, hogy a legerősebb antibiotikumoknak - az úgynevezett carbapenemek - ellenálló szuperbaktériumok már a világ minden régiójában megtalálhatók.
A gyógyszer-rezisztenciát az antibiotikumok helytelen és túlzott használata okozza, mely arra ösztönzi a kórokozókat, hogy új utakat keresve legyőzzék őket. Becslések szerint az egyik legismertebb szuperbaktérium, az MRSA számlájára írható évente mintegy 19 ezer amerikai és körülbelül ugyanennyi európai beteg halála - vagyis több, mint ahányan a HIV/AIDS következtében életüket vesztik.
A WHO szerint egyes országokban - a gyógyszer-rezisztencia miatt a carbapenemek nem hatnak a közönséges, kórházban szerzett, Klebsiella pneumoniae baktérium okozta tüdőgyulladásos, véráram-fertőzéses betegek felénél. Az újszülöttek és intenzív osztályon ápoltak fertőzéseire ugyanez igaz.
Fukuda közleményében azt írta, ha nem tesznek komoly lépéseket a fertőzések megelőzésére és nem változtatják meg az antibiotikumok gyártásának, felírásának és használatának módját, a világ egyre többet veszít a globális közegészségügy javaiból, a következmények pedig pusztítóak lesznek.
Laura Piddock, az Antibiotic Action kampánycsoport igazgatója, a Birminghami Egyetem mikrobiológusa szerint a világnak most úgy kell a veszélyre reagálnia, ahogy az 1980-as években tette az AIDS terjedésére.
"A gyógyszer-rezisztencia legyőzéséhez politikai akaratra, minden érdekelt elkötelezettségére, kutatási és megfigyelési programok jelentős mértékű finanszírozására lesz szükség" - hangsúlyozta Piddock.
Kövesse az Egészségkalauz cikkeit a Google Hírek-ben, a Facebook-on, az Instagramon vagy a X-en,Tiktok-on is!








